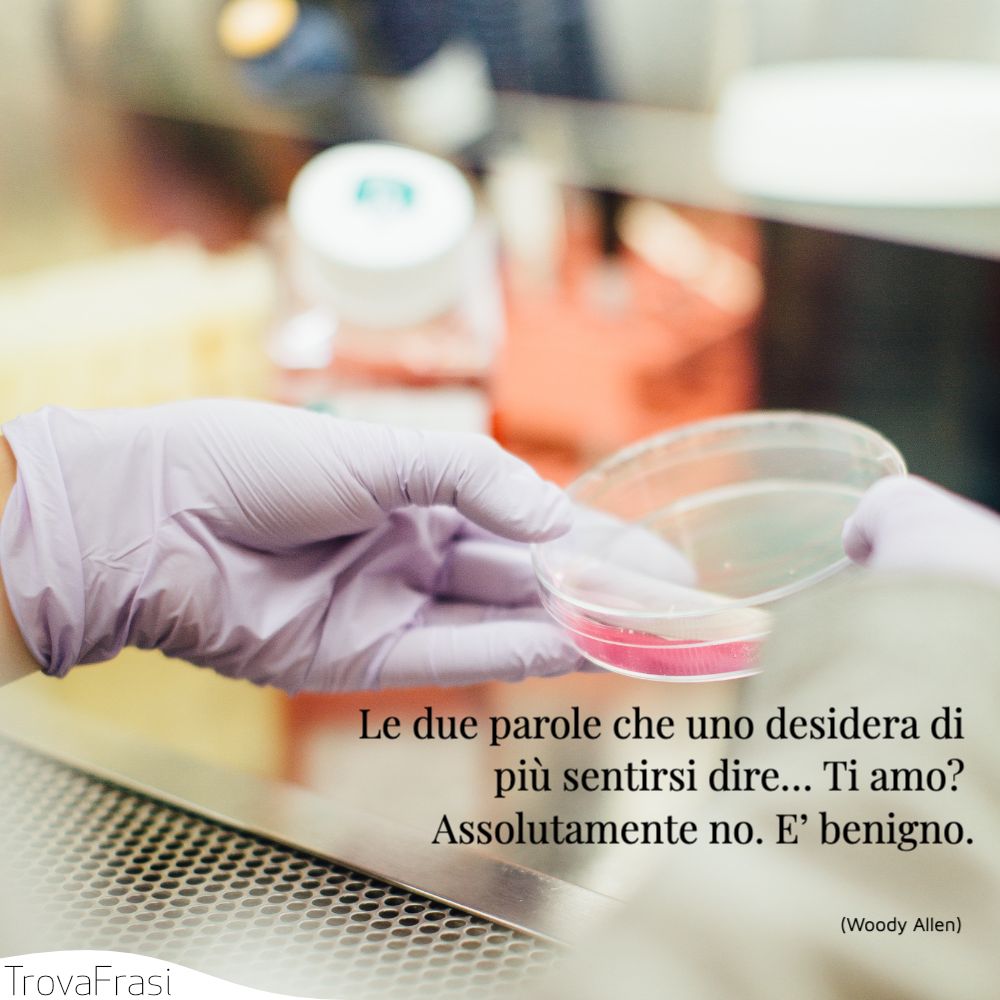

Dire qualcosa che ancora non sia stato detto o scritto a proposito dei medici è un’impresa davvero ardua. Se non ci fossero, infatti, andrebbero inventati con tutto il loro bagaglio culturale, professionale e comportamentale.
Le frasi sui medici celebrano la professione del medico e l’importanza delle medicina per lo sviluppo della società.
Altre frasi sul tema Corpo
- C’è chi ritiene che noi, medici e infermieri che lavoriamo in zone di guerra, dovremmo limitarci a fare interventi chirurgici e medicazioni, senza pensare né prendere la parola.
- O infermo, se il tuo medico nomini erede, guai!
- Come dice Ippocrate: il medico studia le persone, non le malattie.
- Il vino è il balsamo della vecchiaia. Lo hanno detto i proverbi di tutte le nazioni, lo hanno proclamato i medici d’ogni tempo e Galeno lasciò scritto: Sane vinum pueris est alienissimum, ita senibus aptissimum.
- Molti funerali gettano discredito sul medico.
- Diaulo faceva il dottore, ora s’è messo a fare il becchino; quel che fa da becchino, faceva già da dottore.

- Finché gli uomini potranno morire, e ameranno vivere, il medico sarà oggetto di ironia, e pagato profumatamente.
- Farmacista: Complice del medico, benefattore del becchino e fornitore della famiglia dei vermi.
- Fin quando il medico ci proibisce qualcosa, tutto va bene. La situazione diventa seria quando improvvisamente ci permette tutto.
- Cosa guadagni, amico, se invece di quattro scellini ne incassi sei, se quello che hai in più lo devi dare al medico?
- I medici sono i più felici tra gli uomini: la rinomanza proclama i loro successi e la terra ricopre i loro errori.

- I medici più pericolosi sono quelli che, da attori nati, imitano con perfetta arte di illusione il medico nato.
- Dio e il Dottore, noi adoriamo allo stesso modo
Ma solo in caso di pericolo, non prima;
Passato il pericolo, entrambi sono allo stesso modo ricambiati,
Dio è dimenticato, e il Dottore disprezzato. - Se non hai medici a portata di mano, ti facciano da medici queste tre cose: mente serena, riposo e moderazione nel mangiare.
Altre frasi sul tema Corpo
- Frasi sul vivere bene e il benessere del corpo
- Frasi sui viaggi e la libertà di poter partire e vedere il mondo
- Frasi sul fine settimana: che il weekend abbia inizio!
- Frasi sulla lettura: cibo per la mente e lo spirito
- Frasi su Mahatma Gandhi: colui che ha cambiato il mondo
- Frasi su Edgar Allan Poe: il padre del gotico
- Frasi sull’affrontare la vita e rialzarsi dalle difficoltà
- L’incontro tra medico e malato si attua attraverso un corpo anatomico che serve, contemporaneamente, come soggetto di indagine e come secondo polo del rapporto; si tratta cioè, di un incontro tra un soggetto ed un corpo cui non viene data altra alternativa oltre essere oggetto agli occhi di chi lo esamina. Estraneo dunque a quest’ultimo quanto al soggetto che lo significa, pur essendo insieme il momento cruciale e la finalità stessa della relazione.
- Da come tasta il polso si vede il buon medico.
- Ascoltare un paziente non richiede solo strumenti medici.

- Mentre i medici si consultano, il paziente muore.
- Diagnosi: Talento molto sviluppato fra i medici che consiste nell’intuire l’entità del conto in banca del paziente in modo da poter stabilire quanto a lungo debba essere ammalato.
- Attenti al medico che ha un rimedio per tutto.
- Il medico dovrebb’essere sacerdote e magistrato e oratore e milite nel suo ministero; pietà, sapienza, coraggio, eloquenza.
- È morta di quattro medici e due farmacisti.

- No, non è il corpo che è ammalato. È l’anima! Piuttosto che un medico… un confessore.
- Nella patologia nervosa, un medico che non dice troppe stupidaggini è un malato guarito per metà.
- Quando un medico volge il suo intelletto al male è il peggiore dei criminali: ha il sangue freddo e ha la conoscenza.
- Un medico che, sul suo paziente, non sa altro che quanto questi gli dice, conosce in realtà molto poco. Egli deve saper giudicare dalle sue apparenze esterne le sue condizioni interne. Deve saper vedere l’intimo dell’uomo esterno.
- È compito del medico prolungare la vita e non è suo compito prolungare l’atto della morte.

- La natura causa e cura le malattie, ed è quindi necessario che il medico conosca i processi della Natura, l’uomo invisibile al pari dell’uomo visibile.
- Lo psicanalista è un uomo che, dopo molte sedute con i propri pazienti, sa dirti che cosa gli manca.
- Ho ritirato le analisi del sangue, sopra un medico ha scritto a penna:”ho un cugino che lavora alle pompe funebri, di che ti mando io”
- Il lavoro più facile al mondo è quello del medico legale. Interventi chirurgici su persone decedute: che cosa potrebbe andarti storto? Sentirne ancora il battito?
- Uno dei sintomi dell’arrivo di un esaurimento nervoso è la convinzione che il proprio lavoro sia tremendamente importante. Se fossi un medico, prescriverei una vacanza a tutti i pazienti che considerano importante il loro lavoro.
- E’ facile ottenere un migliaio di prescrizioni, ma è difficile ottenere un unico rimedio.

- Una volta il medico era come un cecchino: al massimo ne faceva fuori uno alla volta. Poi è arrivata la Mutua ed è come se gli avessero messo in mano una mitragliatrice. Una strage.
- Il mio dottore dice che facendo le scale a piedi si guadagnano minuti di vita. Rampa dopo rampa ho guadagnato due settimane, durante le quali pioverà sempre…
- Trent’anni prima, Bernard Shaw già lo rilevava: i medici, diceva, hanno smesso di guarire per impadronirsi dell’intera vita dei loro pazienti.
- “Quale paura ti opprime?”
“Il medico è lei”
“Ma chi deve guarire sei tu” - Dottori: chi ha lasciato l’aorta aperta?

- Nulla accelera tanto la guarigione quanto le parcelle periodiche del medico.
- I dottori hanno fatto tutto quello che hanno potuto, ma nonostante questo sono ancora vivo.
- Sono diciamo un ipocondriaco e facendo di necessità-virtù sono diventato un eccellente prontuario medico parlante. Quando un amico ha qualche malessere mi chiama e io dispenso consigli.
- Con grande efficacia operano i medici in cui moltissimi confidano; i malefici, che pure non toccano chi li disprezza, penetrano in chi li teme.
- Il dolore va trattato non come un guizzo o una contrazione muscolare, ma come il grido di un’anima, a cui un altro fratello, il medico, accorre con l’ardenza dell’amore, la carità.
- Le due parole che uno desidera di più sentirsi dire… Ti amo? Assolutamente no. E’ benigno.

- La vita degli uomini è cosa miserevole, come vento di tempesta l’attraversa l’incontenibile avidità di guadagno: oh, se contro di essa si fossero uniti tutti i medici per curare un male che è più grave della follia perché viene benedetto, mentre è una malattia e produce del male.
- Quando tutto sarà finito, tornerò in Africa. Resto il medico dei dannati della Terra. Prestato alla Protezione civile. Destra o sinistra, non importa.
- Il più grande errore nel trattamento delle malattie è che ci sono medici per il corpo e medici per l’anima, anche se le due cose non dovrebbero essere separate.
- Quando i medici hanno un paziente con la cancrena non esitano ad amputargli una gamba pur di salvargli la vita. Talvolta l’unica azione possibile è il minore tra due mali.
- I medici mettono delle droghe che non conoscono in un corpo che conoscono ancora meno.

- Il medico pietoso fa la piaga puzzolente.
- Ci sono soltanto due tipi di dottori: quelli che esercitano col loro cervello e quelli che esercitano con la loro lingua.
- Un medico che, invece di erudizione e genio, non ha altro che arroganza, è un vero ciarlatano.
- I medici sono gli uomini d’affari della scienza. Alcuni medici hanno la passione della loro scienza: ne sono i poeti.
- Medico: Uno a cui affidiamo le nostre speranze quando malati e i nostri cani quando sani.
- La medicina è la scienza dell’incertezza e l’arte della probabilità.

Le migliori citazioni sui medici con autore
Le frasi sui medici di cui non conosciamo la fonte
Altre frasi sul tema Corpo
- Frasi sul vivere bene e il benessere del corpo
- Frasi sui viaggi e la libertà di poter partire e vedere il mondo
- Frasi sul fine settimana: che il weekend abbia inizio!
- Frasi sulla lettura: cibo per la mente e lo spirito
- Frasi su Mahatma Gandhi: colui che ha cambiato il mondo
- Frasi su Edgar Allan Poe: il padre del gotico
- Frasi sull’affrontare la vita e rialzarsi dalle difficoltà
- Frasi per mettere di buonumore e far tornare il sorriso
- Frasi sulla malinconia: un altro lato della tristezza
- Frasi sull’umanità e la costruzione della società